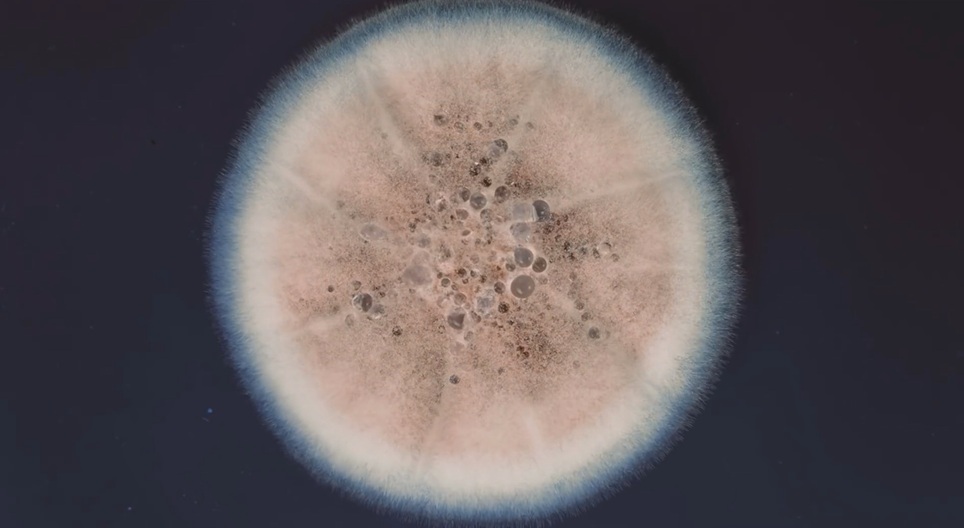

카트가 비어 있습니다.
Penicillin
Penicillin is the most widely recognised antibiotic. Antibiotics kill or inhibit the growth and synthesis of bacteria. Penicillin is produced as a metabolite of a certain species of Penicillium mould which is grown on an agar-agar substance.
00:39
7 ~ 12 학년
검색어
mozaLink
/웹 링크